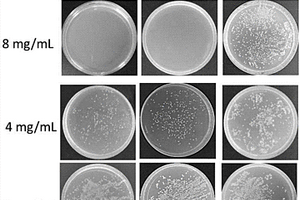

全部

 733
733
 0
0
一种单层纳米磷酸锆改性重质氢氧化镁及其制备方法,改性重质氢氧化镁由单层磷酸锆纳米片和氢氧化镁颗粒组成。本发明一种单层纳米磷酸锆改性重质氢氧化镁的制备方法,通过超声震荡或氮气鼓泡液相剥离法制备单层磷酸锆纳米片,在表面活性剂存在下将氢氧化镁粗粉研磨至0.1‑10 um细粉后,加入改性单层磷酸锆纳米片分散液配成固含量60-80%的浆料,湿法搅拌研磨获得粒径为0.05‑2微米的改性氢氧化镁。本发明充分利用纳米磷酸锆的催化成炭作用,在保持氢氧化镁阻燃作用的同时,通过纳米磷酸锆催化作用,提高聚合物在燃烧时的成炭能力,进而更好地提高聚合物复合材料的阻燃性能。

 791
791
 0
0
本发明公开了一种具有可磨耗封严功能的室温固化型涂料,是由A、B两种组份混合而成的腻子状材料;其中A组分是由液体橡胶、液体环氧树脂、滑石粉组成;B组份胺类固化剂。使用时,将A组分与B组分的质量比为100:8~100:15充分混合,并采用刮涂的方法施涂到部件表面,室温充分固化即得可磨耗封严涂层。该材料对金属及复合材料基材具有良好的附着力,具备优良的可磨耗性及耐气流冲蚀的性能,用于航空发动机风扇/增压级部位,当涂层与运转零件摩擦时,涂层本身可被磨削,而不使零件受到磨损,同时可控制转动部件与非转动部件之间的间隙,起封气和封油的作用,减少压缩气流的损失和滑油的漏失,以提高发动机的效率、降低发动机油耗。

本发明涉及一种硫化铟锌‑氮掺杂石墨烯泡沫复合光催化材料及其制备方法和应用。该复合光催化材料包括三维的氮掺杂石墨烯泡沫和垂直布设在氮掺杂石墨烯泡沫表面的二维硫化铟锌纳米片。其制备为:聚氨酯海绵亲水处理后,浸泡在氧化石墨烯悬浮液,干燥后煅烧,通过O2等离子清洗即得三维氮掺杂石墨烯泡沫;然后与无机锌盐、无机铟盐和含硫有机物混合后进行水热反应,后处理即得硫化铟锌‑氮掺杂石墨烯泡沫复合光催化材料。该复合材料在模拟太阳光的照射下表现出优异的光催化活性,同时具有足够的紫外‑可见‑近红外光光热转换效率,增强了对太阳光的利用效率,用于光催化还原二氧化碳催化效果好。

 690
690
 0
0
本发明公开了一种维纶织物基石墨烯/二氧化锰电极材料的制备方法,包括以下步骤:(1)氧化石墨烯涂覆处理维纶织物;(2)还原氧化石墨烯:a、在80‑100℃条件下,将氧化石墨烯涂层维纶织物浸入还原剂溶液中1‑2h,取出水洗、烘干;b、再置于700‑900W微波炉中高火加热1‑3s,得到石墨烯涂层维纶织物;(3)沉积二氧化锰:采用电化学沉积在石墨烯涂层维纶织物表面沉积二氧化锰。本发明采用石墨烯‑维纶复合材料作为电极集流体,提高了电极材料的柔性性能,并且通过无毒简易的二次还原以及环境友好的电化学沉积二氧化锰金属氧化物,使得电极材料电化学性能大大提升,为进一步开发环保、柔性、轻质、卓越性能的柔性电容器、电池电极提供基础。

 904
904
 0
0
本发明公开了一种功能性细菌纤维素的制备方法,属于新功能材料技术领域。该方法是将6‑羧基荧光素与葡萄糖合成为6‑羧基荧光素‑葡萄糖;将6‑羧基荧光素‑葡萄糖添加到发酵培养基中;向添加6‑羧基荧光素‑葡萄糖的发酵培养基接种木葡糖酸醋杆菌,通过静态培养使木葡糖酸醋杆菌利用6‑羧基荧光素‑葡萄糖原位发酵合成功能性细菌纤维素。与传统功能性复合材料制备方法相比,本发明方法制备的功能性细菌纤维素化学性能更稳定,应用效果更好,此外其在紫外光下发出绿色荧光,这在防伪标识方面有一定的应用前景。本发明为合成新的功能性细菌纤维素材料提供研究模型,同时也为其他生物合成系统原位合成功能性材料甚至功能性药物提供思路。

 1182
1182
 0
0
本发明涉及一种水性电镀光油及其制备方法,按照质量份数计包括如下组分:水性丙烯酸树脂45~55份、水性聚氨酯/有机蒙脱石复合材料10~20份、三乙醇胺0.5~1.5份、水性流平剂0.2~0.6份、消泡剂0.1~0.3份、附着力促进剂3~8份以及稀释剂20~40份。本发明具有对人体无害、对环境无污染的效果。

 1014
1014
 0
0
本发明涉及电热器件领域,具体是一种锻造金属多层复合板半导体加热器件及应用该器件的电器,包括锻造金属多层复合板、半导体加热组件和多点温度检测系统;锻造金属多层复合板由两种或两种以上不同热形变率、不同厚度的金属材料,叠加成三层或三层以上的结构,采用高温加热、模内锻造、压力封边或焊接封边的方式制成的一种高度致密的复合材料。本发明采用锻造金属多层复合板,一面作为半导体加热组件的附着载体,另一面作为热量输出传导或辐射面,克服了传统单层金属板半导体加热器在生产和应用过程中受热和冷却交替过程中金属板产生应力翘曲变形、热胀冷缩,避免了半导体加热组件因金属载体形变而局部折断、脱落而导致局部过热损坏。

 1098
1098
 0
0
本发明公开了一种环保纳米抑菌PVC木塑板材,它是由下述重量份的原料组成的:木粉30‑40、PVC120‑150、硬脂酸2‑4、柠檬酸三丁酯10‑14、聚苯并咪唑0.5‑1、ac发泡剂10‑15、甲壳素掺杂poss改性抑菌材料20‑30。本发明可以很好的改善复合材料在各基体间的分散性能,且poss的力学性能好,能够有效的提高成品的力学强度。本发明的材料环保性好,不含有毒的增塑剂原料,使用安全性高。

 638
638
 0
0
本发明公开了一种锂离子电池用纳米多孔复合负极材料,包括SiO粉体、Zn粉体、石墨和柠檬酸。本发明稳定了材料体系的电接触,促进NP‑SSCG复合材料体系中各组分的性能发挥,最大程度上缓解材料在充放电过程中的体积膨胀,使得材料获得较好的电化学稳定性。其中纳米多孔结构可增加材料与电解液的接触面积,提高锂离子的嵌入、脱出速度,SiO材料循环稳定性好、Si基负极材料容量高、碳材料和石墨导电网络结构稳定,大幅度克服高容量负极材料首次库伦效率低、循环稳定性差的缺陷。本发明在制备过程中研发了生产工艺稳定可靠、可商业化大规模生产的工艺路线,在高能量密度锂离子电池领域具有广阔的应用前景。

本发明公开了一种基于激光选区熔化技术制备石墨烯增强铝合金材料的方法,属于复合材料制备技术领域,包括以下步骤:S1、将石墨烯和分散剂加入去离子水中,超声振荡,得石墨烯悬浮液;S2、将铝合金粉末加入石墨烯悬浮液中,得石墨烯/铝合金混合液,将混合液球磨、干燥,得石墨烯/铝合金复合粉末;S3、将石墨烯/铝合金复合粉末用于选区激光熔化成形,得石墨烯增强铝合金材料。本发明上述方法提高了基体与增强相颗粒之间的润湿性和界面结合强度,促使形成紧密结合的陶瓷/金属连续界面,大幅提高材料的机械性能。

 820
820
 0
0
本发明提供了一种硫酸铜电镀废水的处理方法,步骤如下:(1)将硫酸铜电镀废水依次经过活性炭和离子交换树脂吸附床,得到酸性废水;(2)向步骤(1)得到的酸性废水中加入乙二胺四乙酸钠,溶解后调节pH为1‑2,得到溶液A;(3)将PET粉末溶解于溶剂中,反应后清洗干燥得到改性PET粉末;(4)将步骤(3)得到的改性PET粉末加入到步骤(2)得到的溶液A中,加入硫代硫酸钠溶液,反应后过滤得到滤渣和滤液;(5)将步骤(4)得到的滤液利用离子交换法处理。本发明以改性PET粉末为基体,在水溶液中与铜离子的前驱体反应,使得铜离子在改性PET粉末上原位生成硫化亚铜/聚酯复合材料。

 1126
1126
 0
0
本发明公开了复合型筛板骨架、热塑性弹性体筛板及相应的制备方法;复合型筛板骨架包括工程塑料和纤维的复合材料骨架。其制备方法是以工程塑料和纤维为原料采用注塑成型工艺制备复合型筛板骨架。热塑性弹性体筛板包括复合型筛板本体和筛板骨架;筛板本体为热塑性弹性体材料;筛板骨架设在筛板本体内。热塑性弹性体筛板的制备方法是采用注塑成型工艺制备筛板骨架;再将筛板骨架置于用于制备热塑性弹性体筛板的模具内,以热塑性弹性体材料为原料采用注塑成型工艺,获得热塑性弹性体筛板。筛板整体具备足够的强度和回弹性,筛板骨架和筛板本体连接紧密,不会分离剥落,延长了使用寿命。

 715
715
 0
0
本发明涉及一种软骨组织仿生基质及其制备方法,所述软骨组织仿生基质由聚己内酯、壳聚糖、β‑甘油磷酸钠和软骨细胞组成;先将壳聚糖和β‑甘油磷酸钠反应后,再加入聚己内酯混匀,复合物中再混入软骨细胞,最后细胞能和复合材料有良好的相容性,植入动物体内也充分显示的细胞的生物活性,且无排斥反应。提供了一种既可注射又可以应用3D打印手段植入的软骨组织仿生基质。

 1103
1103
 0
0
本发明提出一种用于室内空气净化的改性光触媒材料及制备方法,所述改性光触媒材料是将硝酸铈和氢氧化高铈分别加入水中,与纳米蒙脱石、分子筛进行吸附反应,完成后将得到的负载有变价稀土离子的复合材料,然后混合研磨后与活性炭粉、聚乙烯醇、钛酸四丁酯加入无水乙醇中反应形成胶体,最后陈化、干燥、煅烧、研磨而制得。本发明提供的改性光触媒材料,可以有效抑制二氧化钛光生电子‑空穴的复合,使得二氧化钛表面的氢氧自由基数量增多,提高了光催化的效率,同时加入了活性炭,能够吸附空气中的甲醛等,利用吸附‑降解协同作用,进一步提升了空气净化效果。

 1011
1011
 0
0
本发明提供了一种用于铜铝复合排的焊接工艺,包括以下步骤:(1)、将需要搭接的铜铝复合排焊接面涂抹专用助焊剂;(2)、在两个焊接面中,选其中一个零件搭接面,涂抹专用焊锡膏;(3)将两件焊接件的搭接面搭接后,用电阻焊机夹紧气缸,通过石墨电极压紧后,进行焊接,完成后置入水中冷却,之后晾干即可完成焊接。本发明解决了铜铝复合排的搭接焊接问题,既保留了电阻焊工艺的高效易操作,又保证了铜铝复合材料在焊接过程不被破坏,焊接面剪切结合强度大于15MPa;通过本焊接工艺,工件尺寸变化可以很容易的通过调节焊接电流大小、焊接时间、脉冲次数等参数来确保焊接质量,还可以改变电极的形状来适应不同形状产品的焊接。

 1020
1020
 0
0
本发明属于复合材料加工成型技术领域,涉及一种碳纤维毡湿法成型的设备。该装置包括碳纤维毡、密闭装置、导流管、贮存器和真空系统。碳纤维毡置于密闭装置中;密闭装置的左右两端分别通过导流管与贮存器和真空系统相连,其中,与贮存器连接的导流管上设有贮存器开关,用于控制树脂的流量,与真空系统连接导流管上设有真空系统开关,用于控制真空系统的开闭。本发明能够对所浸润碳纤维毡所需树脂进行定量控制,实现均匀浸润;通过自动化设备加工产品,降低了人为因素对产品质量的影响的同时,提高了生产效率。

本发明涉及激光技术应用领域,尤其为一种用于激光冲击波结合力检测的可变脉宽高能纳秒脉冲激光器,由CW光纤激光器、EOM调制器、波形发生器、YLF+Glass固体放大器、综合控制器组成。激光器利用CW光纤激光器和EOM调制器组成NP光纤种子源,触发低能量宽脉宽纳秒脉冲激光束;分别利用波形发生器、YLF+Glass固体放大器对脉冲激光束进行削波处理和多级能量放大;通过综合控制器协同控制CW光纤激光器、EOM调制器、波形发生器、YLF+Glass固体放大器,激发宽脉宽高能量纳秒脉冲激光。整个激光器控制精度高、功能模块化、系统集成化、通用性强,可用于不同深度粘接碳纤维复合材料和不同厚度涂层/薄膜等结构的界面结合力检测。

 1019
1019
 0
0
本发明属于纳米材料技术领域,具体为一种核壳结构聚合物纳米环的制备方法。本发明以两亲性嵌段聚合物(其中一嵌段为疏水聚(4‑乙烯基吡啶)或者疏水胺类聚合物)与环状DNA为原料,疏水嵌段在质子化的水/甲醇(或胺类聚合物的良溶剂)环境下先与DNA络合,继续加入不良溶剂水,嵌段聚合物形成以疏水聚(4‑乙烯基吡啶)或疏水胺类聚合物为核的纳米环。本发明可以制备不同尺寸的可剪裁核壳结构聚合物纳米环,制备过程简便,且聚合物纳米环的核可以进行功能化修饰,实现聚合物纳米环的杂化,该聚合物纳米环可以作为模板制备性能优异的复合材料。

 693
693
 0
0
一种透明膨胀型水性阻燃涂料及其制备方法和应用,本发明属于涂料领域,特别是涉及一种环保阻燃涂料及其制备方法和应用的技术领域。本发明的目的是为了解决现有的阻燃涂料在使用过程中存在的含卤素有害有机挥发物释放、脱水催化剂温度偏高导致阻燃效果差、非透明性涂料使用范围受限制的问题。本发明的透明膨胀型水性阻燃涂料由组分A、组分B和涂料助剂组成。其制备方法为先制备组分A,组分B为三聚氰胺甲醛树脂和/或三聚氰胺改性脲醛树脂,将组分A和组分B混合再添加涂料助剂,搅拌均匀,即可得到透明膨胀型水性阻燃涂料。本发明的透明膨胀型水性阻燃涂料用于室内的木结构材料、木塑复合材料、钢结构材料或混凝土结构的阻燃保护。

本发明涉及一种聚晶金刚石复合片的基底材料及其制备方法、聚晶金刚石复合片,属于聚晶金刚石复合片技术领域。本发明的硬质合金复合材料,包括硬质合金衬底层、用于设置聚晶金刚石层的类金刚石碳膜层、设置于硬质合金衬底层和类金刚石碳膜层之间的过渡层;所述过渡层包括金属层、金属键型硬质材料层中的至少一种。本发明的聚晶金刚石复合片的基底材料,表面为用于设置聚晶金刚石层的类金刚石碳膜层,能够大大增强基底材料与聚晶金刚石层的结合强度,延长聚晶金刚石复合片的使用寿命;在衬底层与类金刚石碳膜层之间设置过渡层以增强类金刚石碳膜层与硬质合金衬底层之间的结合强度。

 704
704
 0
0
本发明提供一种精确筛分CO2/N2的方法,是使用离子液体与ZIF‑8所形成的复合材料进行气体分离的方法;其中,所述的离子液体是由1‑丁基‑3‑甲基咪唑阳离子和双三氟甲磺酰亚胺阴离子构成。通过使用离子液体[BMIM][Tf2N]对ZIF‑8笼的占据修饰实现对ZIF‑8笼径的调变,改善了ZIF‑8孔道的分子筛分能力。使用该改性处理后的ZIF‑8材料,实现对CO2/N2的吸附选择性,从而实现分离。

 820
820
 0
0
本发明公开了一种高介电性氧化石墨烯符合密胺树脂的制备方法,包括如下步骤:(1)改性的氧化石墨烯的制备,(2)密胺树脂反应液的制备,(3)含氧化石墨烯的密胺树脂预聚体的制备,(4)氧化石墨烯/密胺树脂复合材料的制备。本发明树脂添加了氧化石墨烯,使得树脂导热系数较未添加氧化石墨烯的树脂提高了42%,使得密胺树脂结构更加稳定,热稳定性有很大的提高;通过添加钛酸钡,提高了树脂的介电性能;本发明生产工艺能够提高氧化石墨烯的分散均匀性,提高了结合强度,提高了密胺树脂的韧性和抗弯性能。

 1042
1042
 0
0
本发明公开了一种新型伸缩转刷曝气机,其特征在于,包括主轴(1),在主轴(1)上设置刷片(2),在主轴(1)两端分别设置尾端轴承座(3)和前端轴承座(4),在轴承座下设置支撑架(5),在前端轴承座(4)旁设置柔性支撑(6),在柔性支撑(6)上设置减速电机(7),在支撑架(5)上设置伸缩装置(8),本发明的有益效果是:本发明设计合理,结构简单。该新型伸缩转刷曝气机在工作时,将达到预期效果,大多主轴都需要有耐高温要求配置,而此发明从材料上达到了要求,主轴采用加强复合材料,使其加固提高使用安全性。

 814
814
 0
0
本发明属于光电化学生物传感器构建领域,涉及一种基于比率原理阳光驱动便携式光电化学传感器的制备。本发明利用银二氧化钛三维氮杂石墨烯水凝胶氮化碳纳米片修饰电极,然后用壳聚糖处理修饰了Ag/TiO2/3DNGH材料的表面,再修饰黄曲霉毒素B1适配体溶液,孵育,用磷酸缓冲溶液冲洗,然后用牛血清白蛋白封闭未结合的活性位点,再用磷酸缓冲溶液冲洗,得到基于比率原理阳光驱动便携式光电化学传感器。银二氧化钛三维氮杂石墨烯复合材料展现了很好的光电活性和稳定性并且构建的基于比率原理阳光驱动便携式光电化学传感器大大减小了外界和内部各种因素的干扰,提高了检测的准确性,通过太阳光驱动,更加方便快捷,能够在室外进行即时检测。

 1091
1091
 0
0
本发明公开了一种加工工艺,本发明涉及管材加工领域,具体涉及一种钢塑复合管填充降噪工艺,所述钢塑复合管填充降噪工艺,包括以下步骤:步骤一:准备原材料;步骤二:调制填充物;步骤三:组装;步骤四:填充;步骤五:后处理;本发明设计合理,提供的一种钢塑复合管填充降噪工艺,所述管材运用钢塑复合材料进行加工,降低了管材变形破损的概率,通过向PVC管内填充隔音效果好的填充物达到隔音降噪的目的。

 831
831
 0
0
一种玄武岩纤维缠绕包覆结构型钢纤维芯柱的微筋,属于新型复合材料领域,微筋包括:芯柱、纤维包覆层、粘结浸润层;芯柱为结构型钢纤维,纤维长度30‑60mm、直径0.5‑0.9mm、长径比不小于50;玄武岩连续纤维沿结构型钢纤维面螺旋缠绕包覆形成纤维包覆层;包覆纤维包覆层的芯柱在粘结浸润剂中进行浸润、粘结,形成粘结浸润层,烘干硬化后得到微筋。本发明中微筋芯柱具有较高刚度和较好的力学性能,可避免其在混凝土搅拌时结团;表面压痕提高了芯柱与玄武岩纤维之间的粘结强度,可保证微筋在混凝土基体中的整体受力性能;玄武岩纤维的包覆处理可解决钢纤维的锈蚀难题,提高混凝土的耐久性。

 943
943
 0
0
本发明涉及新型功能材料技术领域,公开了一种提高邻苯二甲酸二辛酯增塑剂合成转化率的催化剂,以六水合氯化钴和四氧化三铁磁性粉末为主要原料,利用磁性氧化铁包覆得到的氧化钴纳米复合材料,催化活化性能强,具有丰富的孔道,比表面积大,用量少,能够催化更多的反应基团,使得邻苯二甲酸二辛酯的转化率达到99.8%以上,合成得到的增塑剂塑化效率高,且由于其磁性,回收利用率高,显著降低了成本,本发明制备得到的催化剂解决了现有邻苯二甲酸二辛酯塑化剂在合成反应中转化率低的问题,能够实现降低邻苯二甲酸酯类增塑剂生产成本以及扩展金属催化剂适用领域的现实意义,是一种极为值得推广使用的技术方案。

 797
797
 0
0
本发明公开一种增强超高分子量聚乙烯耐热导热管材及其制备方法。属于高分子化合物的组合物,包括如下按照重量分数计的原料组分:黏均分子量250‑650万的超高分子量聚乙烯60‑95份,镀铜片状硅酸盐5‑40份,偶联剂0.05‑2份,抗氧剂0.06‑0.5份,润滑剂0.1‑5份,首先将各种原料进行高速混合,然后将混合物料加入到连续密炼挤出机进行挤出成型,挤出的复合材料经过定径,然后冷却至常温进入切割,得到镀铜片状硅酸盐增强超高分子量聚乙烯耐热导热管材,其耐热性能以及导热性能得到很好的提高,同时采用镀铜片状无机填料,降低了生产成本。
925
925
 0
0
本发明公开了一种海藻酸盐基高吸水抗菌材料,按质量百分数计,组分为海藻酸钠30%~90%wt,钙盐2%~40%wt,无机抗菌剂2%~50%wt。制备方法为搅拌混合海藻酸钠,钙盐和无机抗菌剂,加入水搅拌至成胶状,干燥。本发明高吸水抗菌材料是生物基有机无机复合材料,制备方法简单,易于操作,制备过程无废弃污染物,产品和生产均安全环保。
北方有色为您提供最新的江苏无锡有色金属材料制备及加工技术理论与应用信息,涵盖发明专利、权利要求、说明书、技术领域、背景技术、实用新型内容及具体实施方式等有色技术内容。打造最具专业性的有色金属技术理论与应用平台!
 2026年03月20日 ~ 22日
2026年03月20日 ~ 22日  2026年03月20日 ~ 22日
2026年03月20日 ~ 22日  2026年03月25日 ~ 27日
2026年03月25日 ~ 27日  2026年03月26日 ~ 28日
2026年03月26日 ~ 28日  2026年03月27日 ~ 29日
2026年03月27日 ~ 29日 
